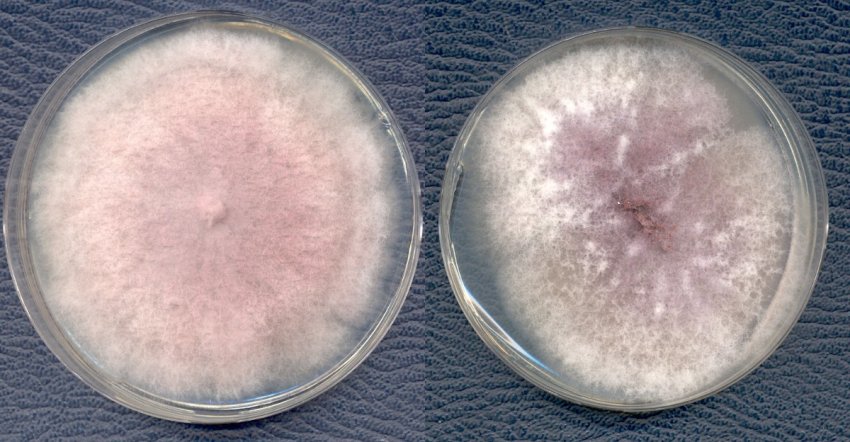

Одним з найпоширеніших грибкових захворювань, що вражають огіркову культуру, є фузаріоз. Які заходи вжити для його попередження і лікування в теплицях або відкритому грунті, читайте нижче.
Чим небезпечне захворювання для огірків?
Зараження грибковими збудниками частіше відбувається через грунт. Фузаріоз вражає судини, що знаходяться всередині пагонів, що призводить до уповільнення росту. Чим молодша рослини, тим більшої шкоди воно завдає їм.
При своєчасному лікуванні проблему можна усунути, але, на жаль, вона стає помітна не на стадії розсади, а коли рослини входять у фазу цвітіння. Головна небезпека полягає в тому, що заражені примірники стадії плодоношення масово починають в'янути і гинути.

У заражених примірників знижується імунітет, внаслідок чого вони стають більш сприйнятливими до інших інфекцій і бактерій. В такому стані огірки нерідко вражає бактеріальне в'янення.
Це захворювання проявляється у рослин зі зниженим імунітетом і не лікується. Крім того, ослаблені огірки піддаються більш часто нападів шкідників. В результаті таких складнощів втрати можуть скласти до 70%.
Причини і симптоми появи
Збудниками хвороби є гриби штаму Fusarium. Поширений недуга повсюдно. В основному вражає культури, вирощувані в теплиці. В умовах відкритого ґрунту проявляється рідше. Грибок переноситься через ґрунт, куди потрапляє разом із залишками рослинності або з водою водойм (якщо нею здійснюється полив).
Спори здатні зберігати життєздатність при мінусових температурах. Головною причиною ураження огірків фузаріозом є недотримання правил агротехніки при вирощуванні культури. Також можливе поширення суперечка за вітром.
Крім цього, причинами, які сприяють розмноженню шкідливих мікроорганізмів, є:
- недотримання сівозміни;
- придбання неякісного насіннєвого матеріалу з рук, вже зараженого фузаріозом;
- закислення або защелоченность ґрунту;
- наявність мікротріщин на кореневій системі або наземної частини рослин;
- дефіцит живлення;
- коливання показників температури і вологості навколишнього середовища та ґрунту;
- напад паразитів — вони здатні переносити спори грибка на своєму тільце.
Спори грибка починають різко збільшувати свою чисельність, при температурі від +18 до +25°С і відносної вологості повітря і грунту понад 70%.

Симптоматична картина зараження фузаріозом:
- При ураженні грибковими суперечками на стадії пророщування насіння спостерігається загнивання паростків, зниження схожості.
- На стадії розсади можуть проявлятися ознаки кореневої гнилі. Однак, в більшості випадків на цьому етапі захворювання ніяк себе не проявляє.
- Дорослі рослини після пересадки в'януть в денний час, вночі відновлюють тургор і до ранку виглядають нормально. Починає в'янути в основному тільки верхня частина куща.
- Чим старше стає рослина, тим сильніше вилягає. Вегетація закінчується набагато раніше.
- При сильному зараженні огірки раптово жовтіють і засихають.
- Плодам, які сформувалися на заражених примірниках, притаманна сильна гіркота.

Способи боротьби
Лікування фузаріозу проводять за допомогою препаратів біологічного і хімічного походження або народними методами. Терапію підбирають залежно від інтенсивності ураження рослин і їх реакції на кошти.
Часто хімічний захист комбінують із народними засобами з метою підвищення ефективності впливу на шкідливі мікроорганізми і збагачення рослин поживними речовинами.
Біологічні препарати
Ця група препаратів безпечна для навколишнього середовища і людини, але не завжди ефективною на стадіях сильного ураження.
найефективніші серед цих засобів:
| Назва препарату | Спосіб застосування та дози |
| «Бактофіт» | 20 мл/10 л води для обприскування аркуша обробляти з обох сторін), всього 7-8 обробок кожні 7 днів, не викликає резистентності |
| «Фітоспорин» | 10 г/5 л води для обприскування по листу, кратність обробок — 3, з інтервалом в 10 днів |
| «Триходермін» | 20 г/5 л води для обприскування протягом усього періоду вегетації з інтервалом у 7 днів, припинити обробки за 21 день до збору врожаю |
Перераховані препарати не сумісні з хімічними фунгіцидами.
Відео: фузаріоз огірків

Хімічні
З хімічних препаратів для лікування фузаріозу застосовують «Фундазол». На 10 л води додають 10 г засобу. Розчину вистачає для розприскування по листу і грунту на 100 м2. Всього проводять 2 обробки з інтервалом 20 днів. Останнє обприскування повинно проводитися не пізніше, ніж за 1 місяць до збирання врожаю.
При використанні фунгіциду потрібно чітко дотримуватися інструкцій і дотримуватися заходів власної безпеки. Хімзахисту доцільно використовувати тільки до формування зав'язі. В більш пізні терміни підвищується ризик отримати отруєння при споживанні продукції.
Народні засоби
Обработка огурцов от болезней народными средствамиЕфективним засобом є деревна зола. Попелом опудривают всі рослини і ґрунт навколо них. Такі обробки можна проводити протягом усього сезону.
Вони не тільки сприяють усуненню шкідливої мікрофлори, але і збагачують тканини рослин, а також грунт калієм і фосфором. Це сприяє підвищенню імунітету і поліпшення якості плодів.
Методи профілактики
Фузаріоз поширюється дуже швидко, тому основні сили варто направити на його попередження.

Профілактичні заходи в першу чергу передбачають виконання всіх правил агротехніки:
- Дотримання сівозміни — не варто висаджувати огірки кілька років підряд на одному і тому ж місці, а також після картоплі, томатів, перцю і баклажанів.
- Ділянку на городі і в парнику потрібно готувати з осені — основне завдання зруйнувати мікрофлору, в якій мешкає грибок. Зробити це можна за допомогою глибокої культивації грунту (20-30 см). Проводити її потрібно мінімум 2 рази. Між перекопками в грунт вносять один з біопрепаратів або 3% розчин мідного купоросу, а також азотовмісні добрива (по 6 ст. л. нітрофоски або по 20 кг свіжого гною на 1 м2).
- Якщо в парнику була спалах фузаріозу, то верхні 20 см ґрунту потрібно замінити на суміш торфу, піску і перегною (1:1:1). Всі стіни і дах у таких випадках обробляють мідним купоросом.
- Контроль кислотності грунту — оптимальний показник рН 5-7. При підвищених показниках, на кожен 1 м2 в осінній період замість азотистих добрив вносять по 600 г деревної золи або 400 г доломітового борошна.
- Посадки огірків, особливо, культивованих в тепличних умовах, не слід загущати. Між рядами має зберігатися відстань мінімум 60 см, між рослинами — 50 див.
- Дотримання режиму поливу.
- Своєчасне внесення добрив у відповідності з фазами вегетації рослин.
- Прополка і розпушування ґрунту після кожного зволоження.
- Своєчасний знімання плодів.
Фузаріоз відноситься до захворювань, що викликається грибком. Найбільш часто проявляє себе при підвищеній вологості в сукупності з коливаннями температурного режиму. Із-за здатності суперечка швидко поширюватися, всі сили городника повинні бути спрямовані на попередження такої проблеми.








